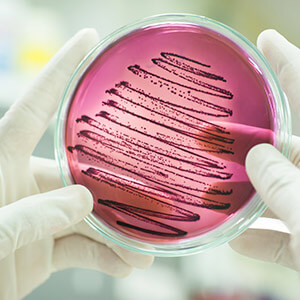

Канал только для зарегистрированных пользователей
Авторизация
Уважаемые коллеги! Трансляция передач Медицинского телевидения проходит по рабочим дням с 9 утра до 19 вечера по московскому времени. Приглашаем ознакомиться с программой телепередач.
Программа передачРекламные банеры
ПУБЛИКАЦИИ
-
31.03.25
Программа Офтальмологической конференции Ерошевские чтения 2025 -
24.06.24
Программа VIII Офтальмологической конференции "Ерошевские чтения 2024" -
31.03.24
Значение повышенной проницаемости кишечника в патогенезе внутренних болезней -
20.02.24
Резервы снижения смертности от сердечно-сосудистых заболеваний. Обзор -
15.02.24
Периоперационное ведение пациентов с нарушениями системы гемостаза. Методические рекоменда ... -
13.02.24
Программа государственных гарантий бесплатного оказания гражданам медицинской помощи на 20 ... -
13.02.24
Здравоохранение в России 2023, официальное издание
НОВЫЕ МОДУЛИ
-

Неметастатический кастрационнорезистентный рак предстательной железы
-

Длительность обучения: 1 час
-

Специализация:
Онкология, ...
-
-

Эвакуационные мероприятия и маршрутизация больных коронавирусной инфекцией или лиц с подоз
-

Длительность обучения: 1 час
-

Специализация:
не указана
-
-
Антибиотикорезистентность: кто виноват и что делать?
-

Длительность обучения: 1 час
-

Специализация:
Инфекционные болезни, ...
-
-

Формулировка диагноза, кодирование по МКБ-10 и учет пациентов с COVID-19 (Временные методи
-

Длительность обучения: 1 час
-

Специализация:
не указана
-



 4317
4317
 31.03.2024
31.03.2024





































